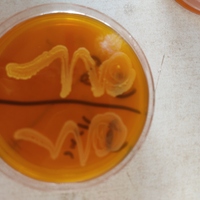
A study on Salmonellosis

Aisha Alhassan Ahmadu
$10/hr
Microbiology Lecturer / academic writer / Medical Virtual Assistant
- Reply rate:
- 100.0%
- Availability:
- Hourly ($/hour)
- Location:
- Minna, Niger State, Nigeria
- Experience:
- 5 years
Portfolio
Uploading...
Converting document...